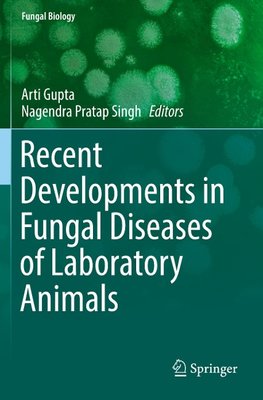
Recent Developments in Fungal Diseases of Laboratory Animals

-
 Anglický jazyk
Anglický jazyk
Recent Developments in Fungal Diseases of Laboratory Animals
Autor: Nagendra Pratap Singh
Fungal growths affect both human and animal well-being. Many natural pathogens of laboratory animals alter host physiology, rendering the host unsuitable for experimental uses. While the number and prevalence of few pathogens have declined considerably,... Viac o knihe
Na objednávku
104.49 €
bežná cena: 109.99 €
O knihe
Fungal growths affect both human and animal well-being. Many natural pathogens of laboratory animals alter host physiology, rendering the host unsuitable for experimental uses. While the number and prevalence of few pathogens have declined considerably, many still turn up in laboratory animals and represent unwanted variables in research. Investigators using laboratory animals in biomedical experimentation should be aware of the profound effects that many of these agents can have on research. What does the future hold regarding the natural pathogens of laboratory animals? The selection of an animal model must carefully address issues of the type of human disease to mimic, the parameters to follow, and the collection of the appropriate data to answer those questions being asked. Overall, animal models of fungal infection will continue to deepen our understanding of how these infections occur.
This book provides a valuable source of information to biological and biomedical scientists and to clinical and doctoral researchers working in the area of fungal infections and diseases of laboratory animal species.
- Vydavateľstvo: Springer International Publishing
- Rok vydania: 2020
- Formát: Paperback
- Rozmer: 235 x 155 mm
- Jazyk: Anglický jazyk
- ISBN: 9783030185886












